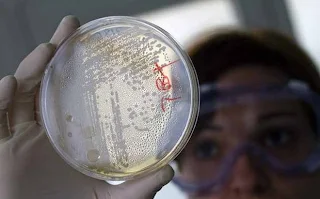

Με το βακτήριο E.coli O157είναι μολυσμένα κρέατα αλλά και κατεψυγμένα σουτζουκάκια στη Βόρεια Ελλάδα. Διαβάστε σε ποιο κατάστημα εντοπίστηκαν. Εντολή ανάκλησης από τον Ε.Φ.Ε.Τ. Τι να προσέξουν οι καταναλωτές
Kατεψυγμένα προϊόντα κρέατος, μολυσμένα με το παθογόνο βακτήριο E. coli O157 εντοπίστηκαν στην Ελλάδα.
Τα προϊόντα εντοπίστηκαν από ελέγχους του ΕΦΕΤ στη Βόρεια Ελλάδα και συγκεκριμένα από την Περιφερειακή Διεύθυνση Ανατολικής Μακεδονίας και Θράκης.
Πρόκειται για κατεψυγμένο προϊόν κιμά από βοδινό κρέας και κατεψυγμένα πικάντικα σουτζουκάκια από βοδινό κρέας, τα οποία διακινούνται από την εταιρεία LIDL.
Ο Ε.Φ.Ε.Τ. απαίτησε την άμεση ανάκληση και απόσυρση του συνόλου των συγκεκριμένων προϊόντων από την ελληνική αγορά και ήδη βρίσκονται σε εξέλιξη οι σχετικοί έλεγχοι.
Παράλληλα καλούνται οι καταναλωτές που έχουν ήδη προμηθευτεί τα προϊόντα αυτά να μην τα καταναλώσουν.
"Οι καταναλωτές δεν πρέπει να ανησυχούν, γιατί όλο αυτό δείχνει πόσο καλά αντανακλαστικά έχει ο ΕΦΕΤ, καθώς κατά τη διενέργεια δειγματοληπτικών ελέγχων και σε συνεργασία με το Κέντρο Ελέγχου και Πρόληψης Νοσημάτων, που έκανε την ανάλυση, εντοπίστηκε η μολυσμένη παρτίδα και ζητήθηκε η άμεση απόσυρσή της", τόνισε ο πρόεδρος του ΕΦΕΤ.
Συγκεκριμένα πρόκειται για:
Kατεψυγμένο προϊόν κιμά από βοδινό κρέας, σε κλειστή συσκευασία των 500 g (2 Χ 250 g), με την εμπορική επωνυμία "Marvest", που διακινήθηκε από τη γερμανική επιχείρηση "Griechenland Rind, Vion Hilden GmbH" στην ελληνική εταιρεία "LIDL Hellas & ΣΙΑ Ο.Ε.".
Το εν λόγω προϊόν έχει αριθμό παρτίδας L91185010 και ημερομηνία λήξης 6-11-2011, και κατεψυγμένα πικάντικα σουτζουκάκια από βοδινό κρέας, σε κλειστή συσκευασία των 1000 gr, με την εμπορική επωνυμία "Marvest", που διακινήθηκε από τη γερμανική επιχείρηση "Vion Convenience GmbH" στην ελληνική εταιρεία "LIDL Hellas & ΣΙΑ Ο.Ε.".
Τέλος, έχει αριθμό παρτίδας L1 102 BT και ημερομηνία λήξης 8-11-2011.
KΕ.ΕΛ.Π.ΝΟ: "Διαφορετικό βακτήριο"
Το βακτήριο E. Coli O157 που ανιχνεύθηκε σε κατεψυγμένα προϊόντα στην Ελλάδα, είναι διαφορετικό από τον ορότυπο Ο104 που προκάλεσε πρόσφατα μεγάλες επιδημίες στη Γερμανία και στη Γαλλία, σύμφωνα με ανακοίνωση του Κέντρου Ελέγχου και Πρόληψης Νοσημάτων (ΚΕ.ΕΛ.Π.ΝΟ).
Στο πλαίσιο της ενημέρωσης του κοινού, το ΚΕ.ΕΛ.Π.ΝΟ. για την ανάγκη τηρήσης των απαραίτητων κανόνων υγιεινής κατά τη διάρκεια χειρισμού και κατανάλωσης τροφίμων, παραθέτει τις παρακάτω χρήσιμες συμβουλές:
-Την υγιεινή των χεριών κατά τον χειρισμό των τροφίμων, πριν από την κατανάλωση τροφής και μετά από τη χρήση τουαλέτας.
-Το καλό μαγείρεμα των τροφών (θερμοκρασία > 70 βαθμών για περισσότερο από 2 λεπτά).
-Τον διαχωρισμό ωμών από μαγειρεμένα τρόφιμα και ιδιαίτερα την προσοχή στον ξεχωριστό χειρισμό των ωμών κρεάτων από ωμά λαχανικά
-Σε περίπτωση που καταναλωτές των παραπάνω προϊόντων εμφανίσουν κλινική συμπτωματολογία γαστρεντερίτιδας συστήνεται η επικοινωνία με γιατρό.
news 247
Δεν υπάρχουν σχόλια:
Δημοσίευση σχολίου